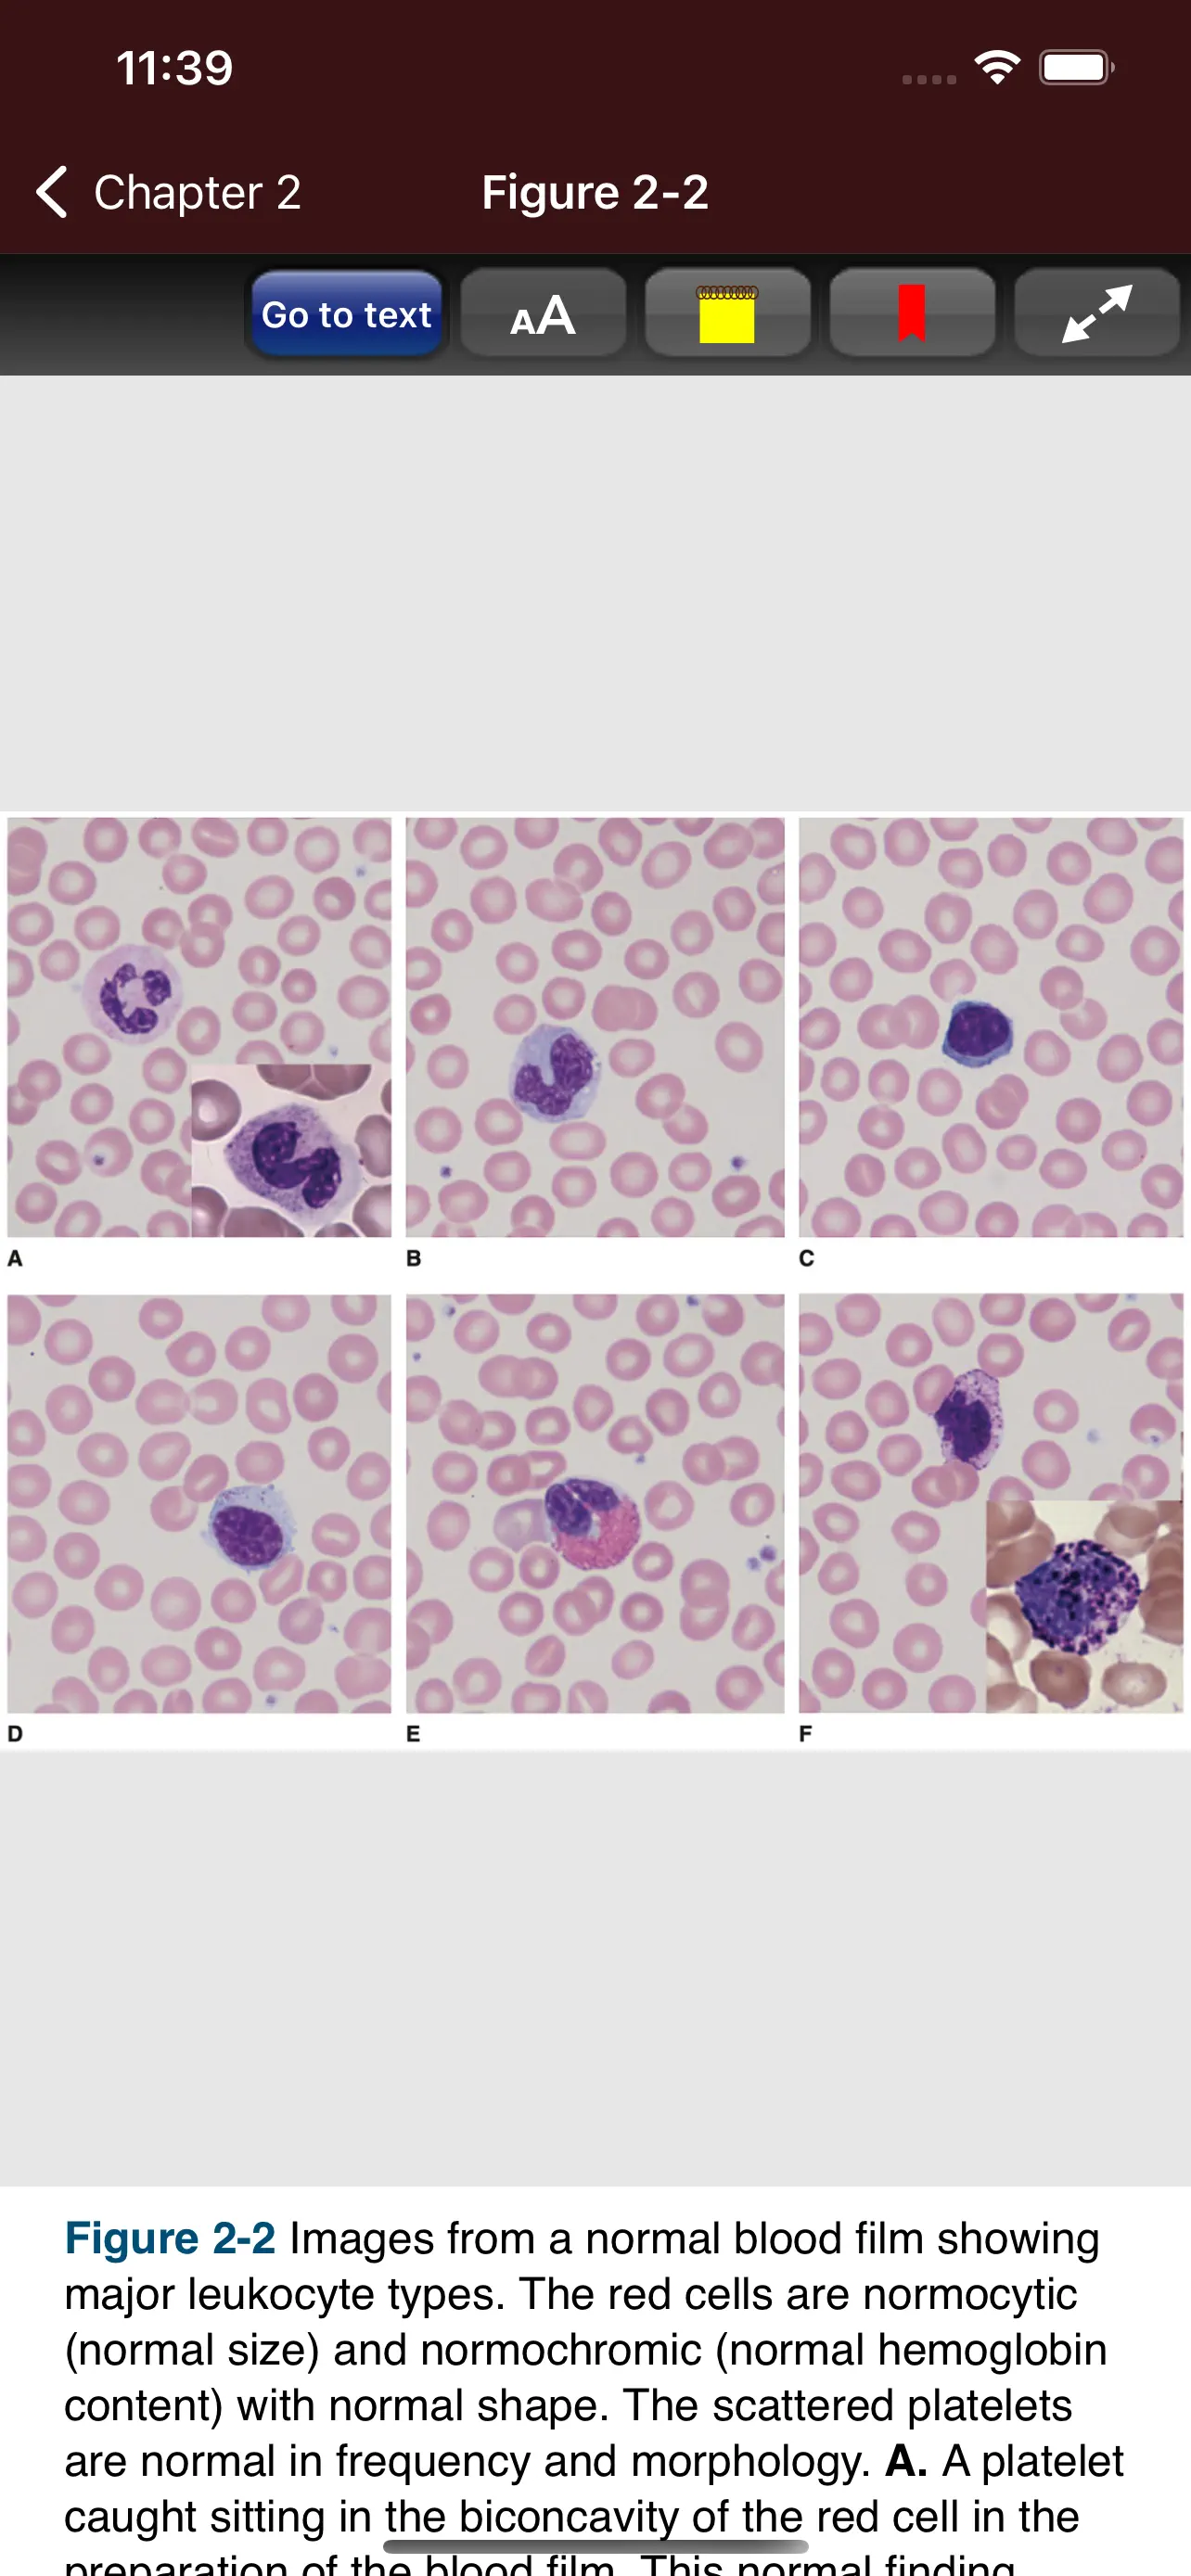

Category:

0
0 Ratings
$399.99
Books
Inkers Full
All the books, brushes and fonts of the tattoo specialized publishing house «Inkers». With this "premium" app, all the current books as well as the incoming ones will be free to download for you. If you want to buy each book separately, please use the Inkers standard app.
Updated: 2 years ago
Released: 11 years ago






0
0 Ratings
$349.99
Books
Law Companion Express
Nigeria largest digital library of Judgments from the Supreme Court, Court of Appeal and High court. It also contains plethora of legislations with weekly updates of case laws and legislations. It is definitely a companion for every lawyer
Updated: 5 years ago
Released: 6 years ago




0
0 Ratings
$349.99
Books
Fitzpatrick's Dermatology, 9/E
The gold-standard text in dermatology, completely updated for today's practice by an all-new editorial board
Encyclopedic in scope, yet skillfully edited to make it easy to read and understand, this trusted classic delivers everything clinicians need to know about skin, skin symptoms, and skin diseases. Presented in full color, Fitzpatrick's covers
Updated: 4 years ago
Released: 6 years ago











0
0 Ratings
$249.99
Medical
Harrison’s Internal Med. 21/E
The Voice of Clinical Reason
Harrison’s Principles of Internal Medicine is the world's most trusted clinical medicine text―and a superb resource for learning the art and science of clinical reasoning. Recognized by healthcare professionals worldwide as the leading authority on applied pathophysiology and clinical medicine, Harrison’s Principles of Internal Medicine provides
Updated: 2 years ago
Released: 3 years ago











0
0 Ratings
$229.99
Books
Atlas of Min. Invasive Surgery
Introducing the most essential all-in-one MIS tutorial and atlas for 21st-century practice
Features:
• Nearly 1,000 state-of-the-art illustrations—all created by esteemed professors of medical illustration at Johns Hopkins University—are designed to help surgeons visualize the procedure as they step to the operating table
• Comprehensive coverage encompassing 62 must-know procedures, each of
Updated: 4 years ago
Released: 6 years ago










0
0 Ratings
$229.99
Medical
Williams Hematology, 10E
The landmark text that has guided generations of hematologists and related practitioners-updated with the latest research findings and improved format and presentation.
Doody's Core Titles for 2021!
Long revered for its comprehensiveness and extraordinary depth of detail, Williams Hematology provides essential coverage of the origins, pathophysiological mechanisms, and management of benign and
Updated: 10 months ago
Released: 4 years ago

0
0 Ratings
$209.99
Medical
Zollinger Atlas of Surgery 11E
Packed with 1,800 images―the gold-standard resource for performing surgical procedures safely and effectively has been fully updated and revised
A Doody's Core Title for 2022!
Zollinger's Atlas of Surgical Operations has been the most trusted text of its kind for more than 50 years. This new edition follows the proven-effective design of
Updated: 2 years ago
Released: 2 years ago











0
0 Ratings
$199.99
Books
Atlas of Emergency Medicine 5E
The most trusted visual guide to emergency medicine—with 2,100+ full-color images and clinical management guidance from leading experts
The Atlas of Emergency Medicine is your “look quick, act fast” guide to accurately diagnosing acute medical problems in emergency practice settings. Packed with the highest-quality images available and fully updated clinical information,
Updated: 4 years ago
Released: 4 years ago











0
0 Ratings
$199.99
Books
Cardiac Surgery in Adults, 5/E
The most comprehensive and current full-color cardiac surgery resource – updated by leading surgeons
In Cardiac Surgery in the Adult, Fifth Edition, the world’s foremost cardiovascular surgeons deliver thorough, up-to-date coverage of operative strategy, decision making, technique, and pre- and post-operative management for treating the adult cardiac patient. Unmatched in both
Updated: 4 years ago
Released: 7 years ago









0
0 Ratings
$199.99
Books
Tintinalli's ER Study Guide 9E
The long-awaited new edition of the world's most widely used and highly regarded textbook and reference of emergency medicine
Tintinalli’s Emergency Medicine is THE essential resource for everyone working in, and teaching emergency medicine. The Ninth Edition provides the depth and breadth of coverage that reflects the complexity
Updated: 4 years ago
Released: 5 years ago











0
0 Ratings
$199.99
Medical
Adams & Victor's Neurology 11e
The definitive guide to understanding, diagnosing, and treating neurologic disease – more complete, timely, and essential than ever
A Doody’s Core Title for 2019!
Adams and Victor’s Principles of Neurology is truly the classic text in its discipline --- a celebrated volume that guides clinicians to an in-depth understanding of the
Updated: 4 years ago
Released: 6 years ago











0
0 Ratings
$189.99
Medical
Pharmacotherapy Principles 6/E
All the main concepts from the landmark Pharmacotherapy: A Pathophysiologic Approach―distilled down to a concise, clinically focused, full-color resource
Pharmacotherapy Principles & Practice uses a solid evidence-based approach to teach you how to design, implement, monitor, and evaluate medication therapy. Updated with additional content and reflecting the latest findings, this sixth
Updated: 3 years ago
Released: 3 years ago











0
0 Ratings
$174.99
Medical
Roberts and Hedges 6th Edition
Roberts and Hedges’ Clinical Procedures in Emergency Medicine continues its long tradition of being the most well-known and trusted procedures manual in emergency medicine. The newly revised 6th edition of this classic medical reference has been thoroughly updated with step-by-step Review, Procedure, and Ultrasound Boxes covering the latest equipment, devices,
Updated: 4 years ago
Released: 9 years ago






0
0 Ratings
$174.99
Medical
Hadzic's Nerve Blocks, 3E
The complete, authoritative, and practical guide to ultrasound-guided nerve blocks – updated to reflect the most current NYSORA initiatives
INCLUDES THREE ATLASES
Hadzic’s is the most comprehensive color guide to the procedures and equipment used in ultrasound guided nerve blocking. Color drawings and photographs are bolstered by concise, step-by-step instruction from the
Updated: 3 years ago
Released: 3 years ago











0
0 Ratings
$174.99
Medical
Schwartz’s Surgery 11/E
The BEST EDITION yet of the #1 text for surgical practice and education
For half-a-century, no other text has provided such a solid grounding in basic science, anatomy, operative techniques, and more recently, professional development and leadership training, as Schwartz's Principles of Surgery. Written by the world's foremost surgeons, this landmark
Updated: 4 years ago
Released: 6 years ago











0
0 Ratings
$169.99
Medical
Atlas of Pediatric ER Med, 3/E
More than 1,000 high-quality clinical images facilitate accurate visual diagnosis in pediatric emergencies
“…an excellent addition for any emergency department that has the privilege to care for children…it will definitely help emergency physicians provide better care to children.” – Annals of Emergency Medicine (reviewing earlier edition)
Pediatric patients can represent as much
Updated: 4 years ago
Released: 5 years ago











0
0 Ratings
$169.99
Books
Treatment of Skin Disease, 5/E
Covering more than 250 of the most common dermatologic conditions from A to Z, Treatment of Skin Disease, 5th Edition, by Drs. Mark G. Lebwohl, Warren R. Heymann, John Berth-Jones, and Ian Coulson, is your go-to resource for authoritative, evidence-based treatment strategies in your daily practice. This award-winning text provides
Updated: 4 years ago
Released: 6 years ago










0
0 Ratings
$139.99
Books
Obstetrics, 6th Edition
Highly readable, well illustrated, and easy to understand, Obstetrics: Normal and Problem Pregnancies remains your go-to choice for authoritative guidance on managing today’s obstetric patient. Reflecting the expertise of internationally recognized authorities, this bestselling obstetrics reference has been thoroughly revised to bring you up to date on everything from ultrasound
Updated: 4 years ago
Released: 9 years ago




